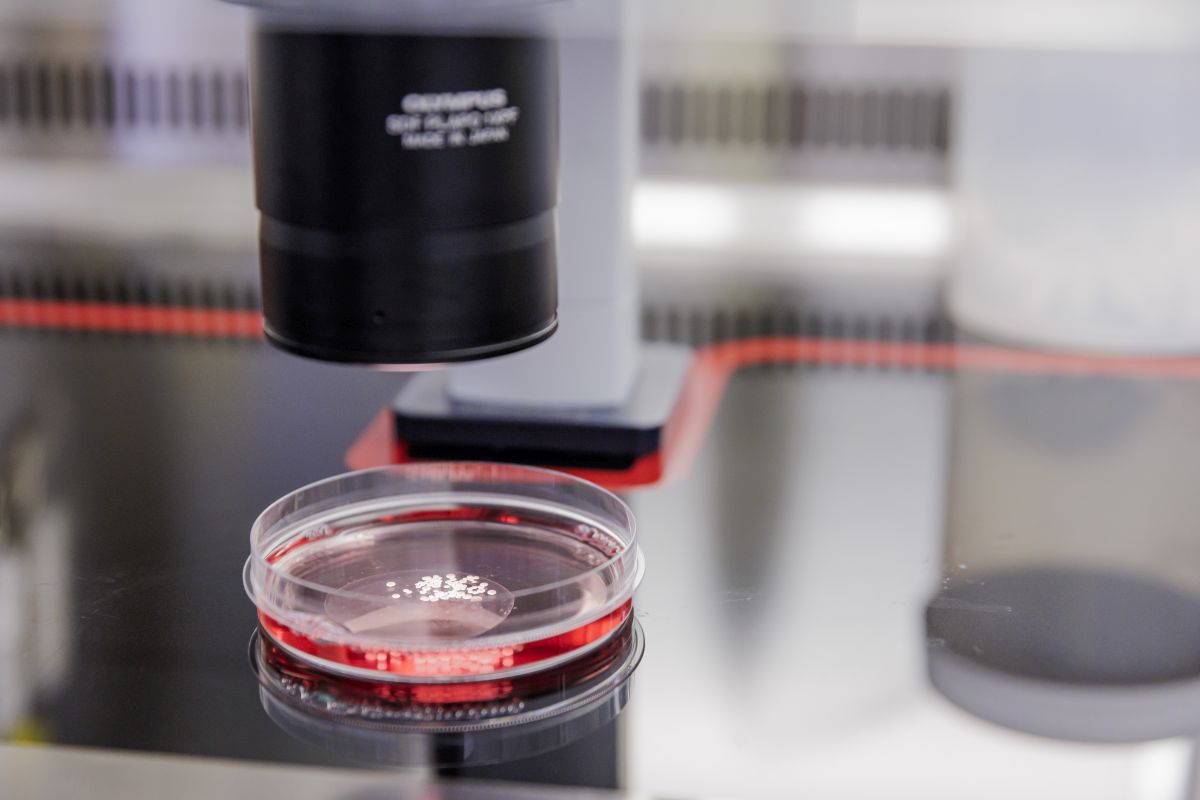
Im Labor. (c) Monique Wüstenhagen

Lange Nacht der Wissenschaften 2026
#LNDW26
LABORFÜHRUNGEN • EXPERIMENTE ZUM MITMACHEN • VORTRÄGE • BIOLOGIE IN STRAHLENDEN FARBEN • STAMMZELL- & RNA-FORSCHUNG • LABOROLYMPIADE • KUNST TRIFFT WISSENSCHAFT • BEGEHBARES VENENMODELL • PUB-QUIZ – TOM & DARREN • SCIENCEMAGIE-SHOW: MAGNETISMUS • FÜR KINDER: EXPERIMENTIEREN & STAUNEN AB 16 UHR

Programm des Schülerlabors
Mikroskopieren, pipettieren, experimentieren - vielfältige Angebote zum Mitmachen und Ausprobieren. Das Gläserne Labor bietet gemeinsam mit dem Forschergarten und seinen Partnerschulen und den Bucher Forschungseinrichtungen ein Programm nicht nur für Kinder und Schüler:innen zur Langen Nacht der Wissenschaften!
Führungen & Vorträge im Biotechpark
17:30, 18:30, 19:30, 20:30 Uhr
Die Entdeckung neuer Medikamente beginnt am Computer und im Forschungslabor
Willkommen in den Forschungslaboren von Silence Therapeutics! Wir nutzen einen natürlichen Mechanismus menschlicher Zellen, die RNA-Interferenz (RNAi). Hiermit verringern wir die Produktion krankheitsverursachender Proteine, um Krankheiten zu behandeln. Bei einem Besuch in unseren Laboren werden wir Ihnen erklären, wie unsere Medikamente, die sogenannten „siRNAs“ (short interfering RNAs), funktionieren, wie wir diese auswählen, synthetisieren und erste Tests durchführen, um die besten zu identifizieren.
Silence Therapeutics GmbH
Begrenzte Teilnehmerzahl. Anmeldung am Infopunkt im MDC.C erforderlich.
Start: Vor dem Max Delbrück Communications Center (MDC.C) (C83)
18:00, 19:00, 20:00 Uhr
Wenn Strahlung den Tumor trifft – verständlich erklärt
Erleben Sie in nur einer Stunde, wie modernste Strahlentherapie mit winzigen Quellen Großes bewirken kann: Wir geben Ihnen spannende Einblicke in die LDR-Brachytherapie bei Augen- und Prostatatumoren – präzise, effektiv und individuell angepasst. Außerdem erklären wir, wie eine besonders schonende Bestrahlung bei seltenen Augentumoren funktioniert und warum sie für viele Patientinnen und Patienten eine echte Chance bedeutet.
Eckert & Ziegler SE
Start: Vor dem Max Delbrück Communications Center (MDC.C) (C83)
19:00, 21:00 Uhr
Radiopharmazie – Wir bringen Sie zum Strahlen
Sind Sie bereit, Ihre Sicht auf Radioaktivität zu verändern? Werfen Sie mit uns einen Blick hinter die Kulissen der modernen Radiopharmazie: Erfahren Sie, wie aus einem Radionuklid Schritt für Schritt ein hochwirksames Arzneimittel entsteht – präzise entwickelt, sorgfältig geprüft und bereit für den Einsatz in der Medizin.
Eckert & Ziegler SE
Start: Vor dem Max Delbrück Communications Center (MDC.C) (C83)
Kinderprogramm im Biotechpark
16:00 bis 22:00 Uhr
Entdecke die Welt der Radioaktivität: Ein spannendes Abenteuer für kleine Wissenschaftler:innen
Du hast die Möglichkeit, spannende Stationen zu durchlaufen und dabei spielerisch mehr über Radioaktivität zu erfahren und die kleinste pharmazeutische Fabrik kennenzulernen. Von Experimenten über interaktive Spiele bis hin zu informativen Stationen. Sei dabei und entdecke die Welt der Wissenschaft!
Ort: Eckert & Ziegler SE, Gebäude A7
Hier: Stempelstation
Begehbares Organ
17:00 bis 23:00 Uhr
Die begehbare Vene
Auf einer Länge von etwa 150.000 Kilometern bilden unsere Blutgefäße ein weit verzweigtes Netz aus Arterien, Venen und Kapillaren, das jede noch so entlegene Stelle des Körpers erreicht. Die Venen transportieren u.a. sauerstoffarmes Blut zurück zum Herzen, meist gegen die Schwerkraft. Ähnlich wie die Arterien können sie verstopfen und Thrombosen verursachen. Die Zellen tauschen auch Informationen mit allen anderen Organen aus. Aber wie sieht eine Vene aus? Gemeinsam mit Expert:innen können Gäste ein sechs Meter langes begehbares Venenmodell erkunden und sich über unsere Forschung informieren.
Ort: Max Delbrück Communications Center (MDC.C) (C83), Foyer
Highlight
22:15 Uhr
Tom und Darren – Das Quiz
Tom und Darren - Das Quiz ist das vielseitigste Live-Quiz Deutschlands. Ein großer Spaß für alle Altersklassen! Zum Mitmachen statt zum Zusehen: Es wird in kleinen Teams mit- und gegeneinander gespielt. Dabei geht es um gemeinschaftliches Rätseln. Quizfragen zu Alltags-, Allgemein- und Spezialwissen. Jede:r kann etwas beitragen, das Gruppenerlebnis steht im Vordergrund: Ob Expert:in oder Laie:in, Schüler:in oder Lehrer:in, Handwerker:in oder Manager:in - das beste Team gewinnt! Tom Zimmermann und Darren Grundorf führen unterhaltsam durch das Quiz!
Dauer: circa 60 min
Ort: Auf der Festwiese

Die Anmeldung für Veranstaltungen mit begrenzter Teilnehmendenzahl ist ausschließlich am Veranstaltungstag vor Ort möglich.
Mitmachen
Forschung erleben, wenn die Einrichtungen des Campus Berlin-Buch zur Langen Nacht der Wissenschaften am 6. Juni 2026 ihre Türen öffnen. Es erwartet Sie ein Programm für die ganze Familie mit Mitmachangeboten, Laborführungen, Workshops, Vorträgen, Rundgängen, Live-Quiz und interaktiven Infoständen. Treten Sie in den Dialog mit Wissenschaftler:innen und lassen Sie sich faszinieren von der Welt der Biomedizin.
Die Lange Nacht der Wissenschaften findet auf dem Campus Berlin-Buch am 6. Juni 2026 von 17 bis 23 Uhr statt. Kinderprogramm bereits ab 16 Uhr.
Programm der Forschungseinrichtungen
Seit über 30 Jahren gibt es das Max Delbrück Center in Berlin, es ist ein weltweit führendes biomedizinisches Forschungszentrum. Wir analysieren das System Mensch – die Grundlagen des Lebens von seinen kleinsten Bausteinen bis zu organübergreifenden Mechanismen. So wollen wir Krankheiten vorbeugen, sie möglichst früh erkennen und passgenau therapieren. Wir zeigen Dinge und Orte, die normalerweise nur unseren Wissenschaftler:innen zugänglich sind: Max-Delbrück-Centrum für Molekulare Medizin in der Helmholtz-Gemeinschaft (Max Delbrück Center)
Was hält uns gesund, was macht uns krank? Wie gelangt ein Medikament an seinen Wirkungsort im Körper? Wie kann man Viren und Bakterien daran hindern, in Zellen und Gewebe einzudringen? Um dies zu beantworten, studieren wir die molekularen Ursachen von Krankheiten. Auf Basis dieser Erkenntnisse entwickeln wir gezielt neuartige Therapeutika, um so die Grundlage für die Medizin von morgen zu schaffen. Während der Langen Nacht der Wissenschaften haben Sie die Möglichkeit, unsere Forschung direkt in unseren Laboren zu erleben und mit unseren Wissenschaftler:innen zu sprechen. Diese Veranstaltung ist für die ganze Familie und besonders für junge Leute geeignet. Leibniz-Forschungsinstitut für Molekulare Pharmakologie
Für Erlebnishungrige und Wissensdurstige: Was es beim Max Delbrück Center, der Charité und dem BIH zu entdecken gibt, finden Sie hier! Berlin Institute of Health at Charité (BIH)

Science Entertainment
17:00, 19:00 Uhr
Rettungsmission im All
Qualm, Laser, Schnee: Ein Potpourri von Experimenten erwartet Groß und Klein bei der Experimentalvorlesung des Schülerforschungszentrum Pankow am Robert-Havemann-Gymnasium.
Für die ganze Familie
Dauer: 45 min
Ohne Anmeldung
Ort: Experimentierhalle in der Mensa (A14)
17:30, 19:00, 20:30 Uhr
Wissen-schafft-Spaß – Mag(ie)netisch: Phantastische Physik - anziehende Zauberei
Metall bremst sich wie von selbst, Dinge schweben, Kräfte wirken ohne Berührung. Magie? …oder doch Physik? In
Eine Show voller Anziehungskraft – überraschend, lehrreich und absolut Mag(ie)netisch!
Ein Wissenschaftsspaß für die ganze Familie
Dauer: circa 45 min
Ohne Anmeldung
Ort: Max Delbrück Communications Center (MDC.C) (C83), Axon 1
RUNDGÄNGE
17:00 Uhr
CAMPUSart – ein Spaziergang
Kunst und Wissenschaftsgeschichte des grünen Gesundheitscampus Berlin-Buch: Auf diesem knapp einstündigen Rundgang stellt Ihnen Dr. Jochen Müller Persönlichkeiten wie Max Delbrück oder die Hirnforscher Oskar und Cecile Vogt vor, erzählt von ihren wichtigsten Stationen, ihrer Forschung und wie sie den Campus Berlin-Buch geprägt haben. Auch Werke namhafter internationaler Künstler und Künstlerinnen auf dem Campus werden Sie sehen – wie zum Beispiel die Leuchttürme von Olafur Eliasson.
Dauer: circa 60 Minuten
Anmeldung nicht erforderlich
Start: Vor dem Max Delbrück Communications Center (MDC.C) (C83)
17:30, 20:00 Uhr
Flechten – Geheimnisvolle Doppelwesen vor der Haustür
Flechten sind die formen- und farbenreichen Lebenskünstler und Extremsportler der Pflanzenwelt, auch hier auf dem Campus. Doch kaum jemandem fallen sie auf, diese geheimnisvollen Doppelwesen aus Pilz und Alge, die mit rund 250 Arten die Berliner Stadtnatur an allen möglichen und unmöglichen Orten bereichern. Schärfen Sie Ihren „Flechtenblick“ und erfahren Sie nebenbei vom botanischen Teil des „Campusart-Projekts“.
Ein Rundgang mit Diplom-Biologe und Naturerlebnisführer Dr. Uwe Lohmeier, Berlin BioScience Academy
Dauer: circa 45 Minuten
Anmeldung nicht erforderlich
Start: Vor dem Max Delbrück Communications Center (MDC.C) (C83)
18:00 Uhr
Die Geschichte des Campus Berlin-Buch
Kaum einer weiß mehr über die Geschichte des Campus Berlin-Buch! Nutzen Sie die Gelegenheit und lassen Sie sich auf einem Rundgang mit Prof. Helmut Kettenmann in längst vergangene Zeiten entführen – von der Krankenhausstadt und den ersten Forschungseinrichtungen in Buch über die Institute der Akademie der Wissenschaften der DDR bis hin zu den Neugründungen nach 1989.
Dauer: circa 60 Minuten
Anmeldung nicht erforderlich
Start: Am Torhaus (A8)
19:00 Uhr
Campus Berlin-Buch: Wissenschafts- und Technologiestandort
Auf dem international renommierten Campus Berlin-Buch dreht sich alles um die Medizin der Zukunft. Rund 1.200 exzellente Wissenschaftler:innen forschen hier auf den Gebieten der molekularen Medizin und Pharmakologie. Ihr Ziel ist es, Erkrankungen früher erkennen, gezielter behandeln oder verhindern zu können. Ärzte- und Forschungsteams wirken dafür Hand in Hand. Im Biotechpark arbeiten etablierte Unternehmen neben Start-ups an innovativen Therapien gegen Krebs oder andere Volkskrankheiten. Lernen Sie den Campus mit Dr. Ulrich Scheller, Geschäftsführer der Betreibergesellschaft, kennen.
Dauer: circa 50 Minuten
Anmeldung nicht erforderlich
Start: Vor dem Max Delbrück Communications Center (MDC.C) (C83)
20:30 Uhr
Historische Mikroskope aus Berlin und Brandenburg
In der ersten Hälfte des 19. Jahrhunderts wurde in Berlin die Zelltheorie entwickelt: Sie besagt, dass Zellen die Grundelemente aller Gewebe bei Pflanzen und Tieren sind. Dies konnte nur mit Hilfe von Mikroskopen etabliert werden. In der Folge entwickelte sich eine neue Industrie in Berlin, die Mikroskop-Herstellung. Lernen Sie die Anfänge der Berliner Mikroskop-Produktion und ihren Einfluss auf die moderne Biomedizin kennen. Es führt Prof. Helmut Kettenmann, Kurator der Ausstellung.
Dauer: circa 60 Minuten
Anmeldung nicht erforderlich
Start: Vor dem Max Delbrück Communications Center (MDC.C) (C83)
20:30 Uhr
Mikrotom, Mikroskop, Mikrowaage - Museum für Wissenschaftsgeschichte
Im Erdgeschoss des Oskar-und-Cécile-Vogt-Hauses sind wissenschaftliche Geräte aus einem Jahrhundert biomedizinischer Forschung ausgestellt, die Etappen der Medizin- und Forschungsgeschichte nachzeichnen. Lernen Sie das Museum für Wissenschaftsgeschichte auf einem Rundgang mit Dr. Ulrich Scheller kennen, der das Museum mit betreut.
Dauer: circa 60 Minuten
Begrenzte Teilnehmerzahl. Anmeldung: zentraler Infopunkt im MDC.C
Start: Vor dem Max Delbrück Communications Center (MDC.C) (C83)
17:00 bis 22:00 Uhr
Wissenschaft auf Rädern
Sie sind nach Laborführungen und Mitmach-Angeboten bereits etwas erschöpft, wollen aber trotzdem den Campus erkunden? Dann steigen Sie in ein Fahrradtaxi und lassen Sie sich von Campus-Mitarbeiter:innen alles zeigen. Sie können Fragen zur Wissenschaft, zum Alltag in einer Forschungseinrichtung oder zur Geschichte stellen. Oder einfach die Fahrt genießen. Völlig kostenlos.
Ort: Auf dem Campusgelände

Service
Die Anmeldung für Veranstaltungen mit begrenzter Teilnehmendenzahl ist ausschließlich am Veranstaltungstag möglich.
16:00 bis 23:00 Uhr
Zentraler Infopunkt
Sie wollen sich für eine Laborführung oder einen Workshop anmelden? Sie haben Fragen zu unseren Angeboten? Dann sind Sie am zentralen Infopunkt richtig! Ab 16 Uhr erhalten Sie hier Informationen über das Programm auf dem Campus Berlin-Buch und können Plätze für Veranstaltungen mit begrenzter Teilnehmendenzahl reservieren. Die Führungen starten vor dem Haupteingang des Max Delbrück Communications Center (MDC.C).
Ort: Foyer, Max Delbrück Communications Center (MDC.C) (C83)
15:30 bis 21:30 Uhr
Abendkasse
Die Tickets zur Langen Nacht der Wissenschaft gelten für alle Veranstaltungen in den teilnehmenden Wissenschaftseinrichtungen. Außerdem können Sie damit die Sonderbusse kostenfrei nutzen. Bei manchen Angeboten wie Workshops und Laborführungen ist allerdings die Zahl der Plätze begrenzt. Dafür müssen Sie sich zusätzlich am zentralen Infopunkt anmelden – natürlich kostenfrei.
Ort: Vor dem Max Delbrück Communications Center (MDC.C) (C83)
Die Lange Nacht der Wissenschaften findet auf dem Campus Berlin-Buch am 6. Juni 2026 von 17 bis 23 Uhr statt. Kinderprogramm bereits ab 16 Uhr.
Veranstaltungsort & Anfahrt:
Campus Berlin-Buch, Robert-Rössle-Straße 10 in 13125 Berlin. Informationen zur Anfahrt finden Sie hier. Während der Langen Nacht der Wissenschaften verkehr zusätzlich ein Sonderbus: S-Bahnhof Berlin-Buch - Campus Buch - S-Bahnhof Buch.
Gastronomie
Es erwarten Sie zahlreiche Foodtrucks, ein Café, ein Restaurant mit Eiscafé, leckeres vom Grill, eine Gulaschkanone und eine Bäckerei.
Alle Informationen zur Langen Nacht der Wissenschaften finden Sie hier
Tickets & Preise
- Reguläres Ticket: 7,50 EUR
gültig für: Erwachsene ohne Möglichkeit einer Ermäßigung. - Ermäßigtes Ticket: 5 EUR
ermäßigt für: Schüler:innen, Auszubildende, Studierende und FSJler:innen, Rentner:innen, Inhaber:innen eines Behindertenausweises (Begleitperson erhält freien Eintritt ohne separate Ticket), ALG I und ALG II-Empfänger:innen und Inhaber:innen des Berechtigungsnachweis, gültig ab 01.07.2022 (mehr Informationen zum Berechtigungsnachweis). Ein entsprechendes Ausweisdokument ist bei der allg. Ticketkontrolle an den Eingängen unaufgefordert vorzulegen. - Kinder unter 6 Jahren (d.h. bis ein Tag vor dem 6. Geburtstag): kostenfrei
gültig für: Kinder unter 6 Jahren bei freiem Eintritt nach Vorlage des Tickets, ausgestellt als Freikarte und eines gültigen Ausweisdokumentes (Lichtbildausweis, Versichertenkarte oder vgl.) - Familienticket: 20 EUR
gültig für: den gemeinsamen Veranstaltungsbesuch von Erwachsenen und Kindern (bis einschließlich 17 Jahren), unabhängig von einer familiären Bindung. Das Familienticket gilt für maximal fünf Personen, darunter nicht mehr als zwei Erwachsene und mindestens ein Kind. Mit den Einzeltickets können getrennt voneinander verschiedene Einzelveranstaltungen besucht werden.
Der Vorverkauf ist gestartet. Die Tickets berechtigen zum Besuch aller Einzelveranstaltungen in den teilnehmenden Wissenschaftseinrichtungen. Außerdem können mit den Tickets die eingesetzten Sonderbusse zur Veranstaltung kostenfrei genutzt werden.
Abendkasse
Auf dem Campus Berlin-Buch finden Sie am Veranstaltungstag vor dem Max Delbrück Communications Center (MDC.C) C83 eine Abendkasse.
Veranstaltungen
Alle Termine09.06.2026, 09:00 bis
11.06.2026, 18:00
Meet the Biotechpark Berlin-Buch at bio:cap 2026
11.06.2026, 14:00 bis
11.06.2026, 17:00
Open Neighbourhoods – Erlebe die Nachbarschaften
06.07.2026, 09:00 bis
06.07.2026, 18:00
Max Delbrück Center Bioengineering Symposium